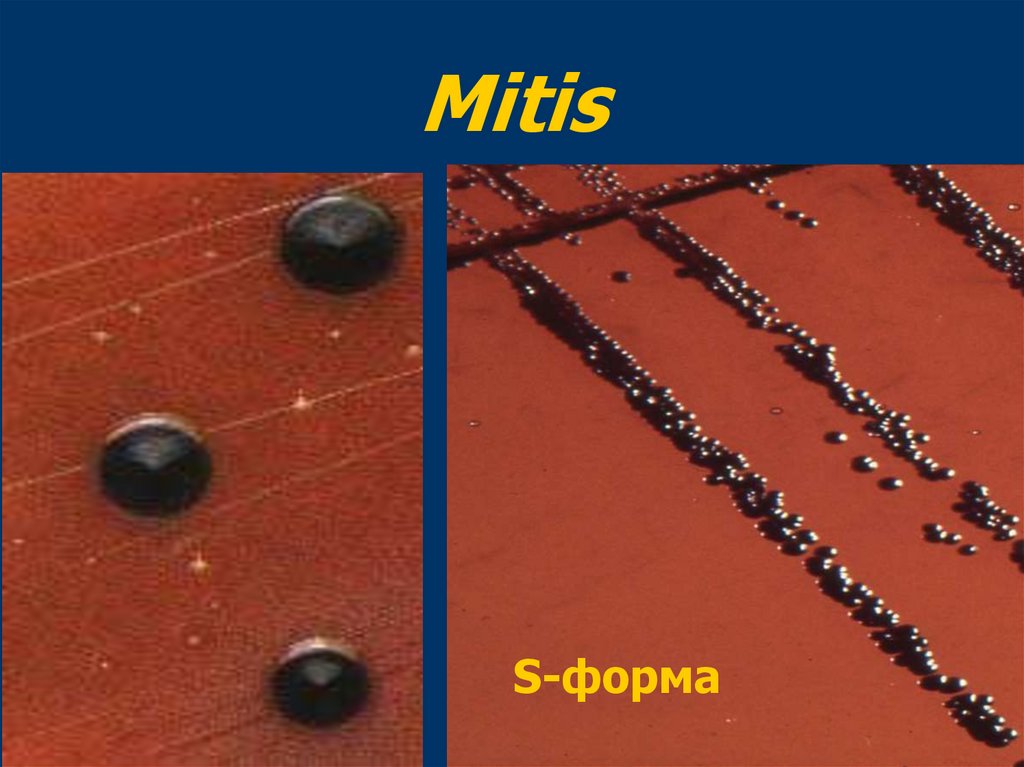
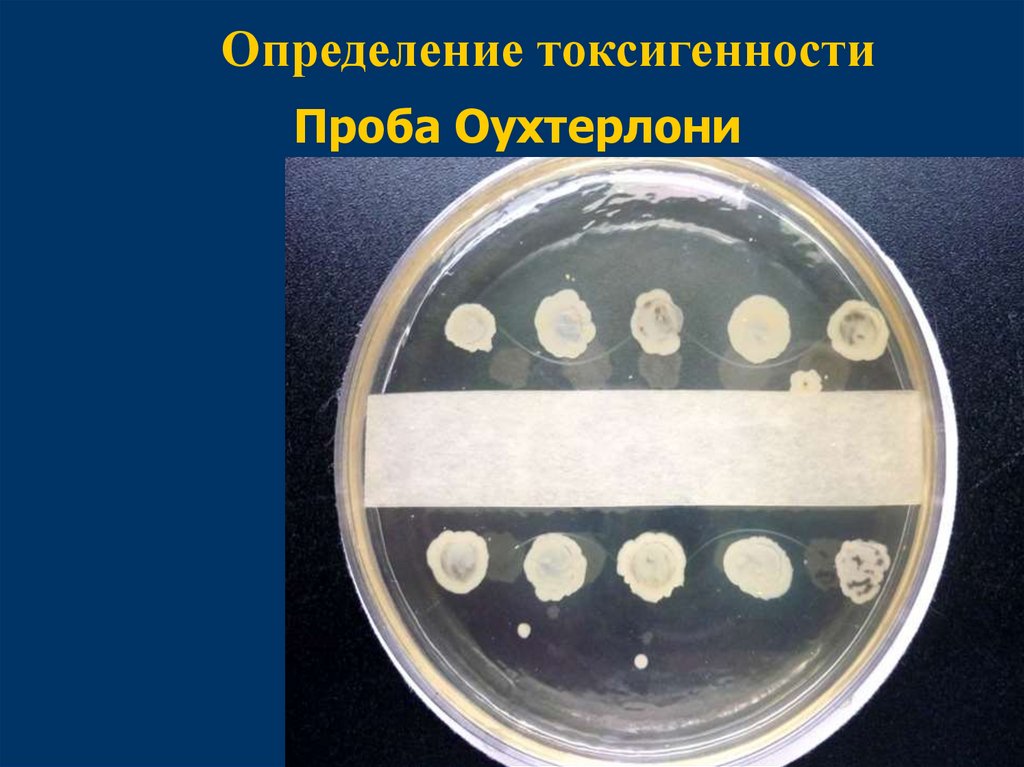
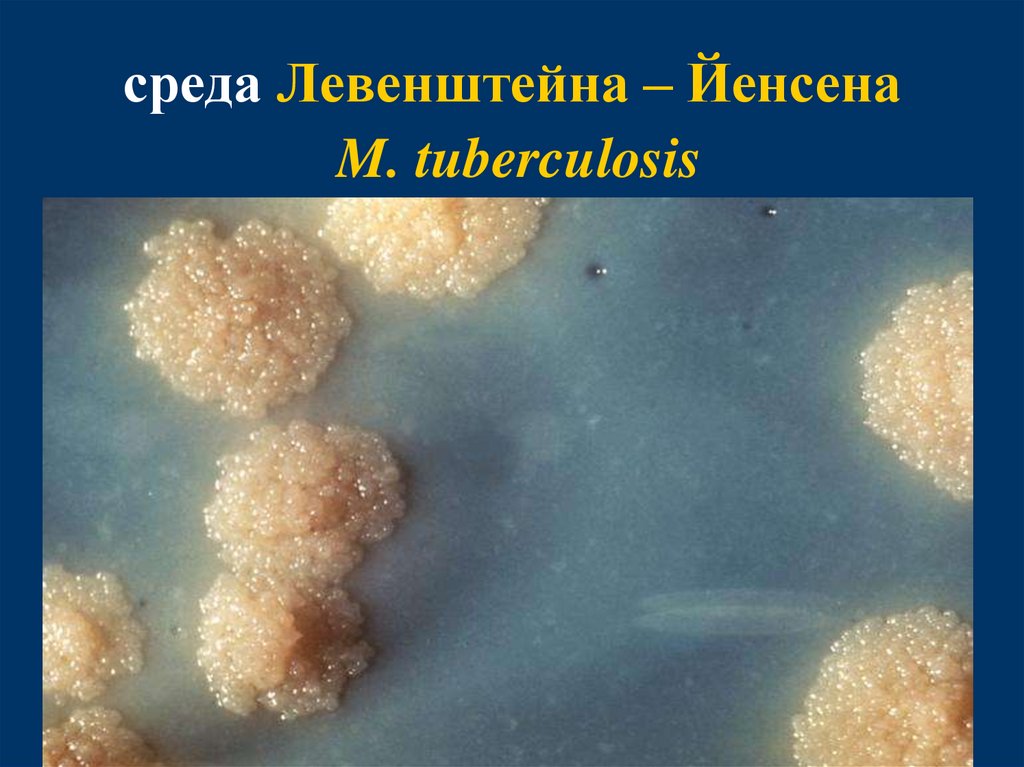

Similar presentations:
Возбудители дифтерии
1. Возбудители дифтерии
УРАЛЬСКИЙ ГОСУДАРСТВЕННЫЙ МЕДИЦИНСКИЙ УНИВЕРСИТЕТКАФЕДРА МИКРОБИОЛОГИИ, ВИРУСОЛОГИИ И ИММУНОЛОГИИ
Возбудители дифтерии
2.
Дифтерия – острое инфекционноезаболевание, вызываемое токсигенными
штаммами дифтерийной палочки,
характеризующееся развитием
фибринозного воспаления в месте
входных ворот, синдромом
интоксикации и осложнениями со
стороны сердечнососудистой, нервной и
мочевыделительной систем
3.
Возбудителядифтерии открыл
Т. Klebs в 1883 г.
Выделил культуру в
чистом виде F. Leffler в
1884 г.
4.
Семейство -Corynebacteriaceae
Возбудитель -
Corynebacterium diphtheriae
5. Морфология
Тонкая прямая или слегкаизогнутая палочка
Утолщены на концах и напоминают
булаву (греч. corynе – булава)
Характерен выраженный
полиморфизм: могут встречаться
нитевидные, ветвящиеся,
кокковидные, дрожжеподобные
формы
Неподвижны
6. Биологические свойства
Спор не образуютИмеют микрокапсулу, пили
Легко окрашиваются
анилиновыми красителями
Грамположительны
В мазках располагаются под
углом друг к другу
Факультативные анаэробы
7. Corynebacterium diphtheriae
8.
9. Зерна волютина
Волютин является запасомпитательных веществ и энергии
(неорганические полифосфаты)
Волютин более интенсивно
воспринимает краситель
10. Зерна волютина
Располагаются на полюсахклетки
Количество зерен у
дифтерийной палочки не
превышает 6
У
непатогенных коринебактерий
– 18 – 20
11.
Выявление зерен волютина(окраска по Нейссеру)
12.
Выявление зерен волютина13.
По морфологическим и культуральнымсвойствам с возбудителями дифтерии
сходна большая группа бактерий рода
Corynebacterium, обозначаемых как:
дифтероиды, коринеформные бактерии,
палочки псевдодифтерии, палочка
Хофманна.
Дифтероиды размещаются параллельно
(в виде "частокола").
14. Культуральные свойства
Среда Ру (свернутая лошадинаясыворотка)
Среда Клауберга (кровяно-телуритовый
агар)
Среда Бучина (МПА + кровь + цистин +
хинозол (для подавления роста кокков) +
метиленовая синька (для подавления
роста дифтероидов)
15. Биологические варианты
gravis – грубыйmitis – тонкий
intermedius - промежуточный
16. Gravis
R-форма17.
Gravis18. Мitis
S-форма19.
intermedius20. Антигенная структура
термолабильныйповерхностный К-антиген
белковой природы
термостабильный
соматический О-антиген
На основании антигенных
особенностей выделяют
58 сероваров
21. Факторы вирулентности
поверхностные структуры липидной ибелковой природы
ферменты агрессии (нейраминидаза)
гемолизин и некротоксин
гистотоксин, являющийся одним из
наиболее сильных биологических ядов
летальная доза составляет 0,5 мг/кг
массы тела
22. Способность к токсинообразованию
Проявляют лишь лизогенныештаммы C.diphtheriae,
инфицированные бактериофагом
(β-фаг), несущим ген tox+ ,
кодирующий структуру токсина.
23.
Дифтерийный фаг tox+24. Патогенез
Входными воротами являются:слизистые оболочки верхних
дыхательных путей (миндалины, зев,
носоглотка, гортань, трахея),
конъюнктива глаз,
кожа наружного слухового прохода,
раневая поверхность,
слизистая гениталий.
25. Патогенез
Коринебактерии локализуются в местевнедрения и продуцируют экзотоксин,
который вызывает некроз эпителия.
Если процесс развивается на слизистой
дыхательных путей, покрытых
однослойным цилиндрическим
эпителием, возникает крупозная пленка,
рыхло связанная с подлежащей тканью.
В полости рта, зеве, глотке, где слизистая
выстлана многослойным эпителием,
образуется дифтеритическая пленка,
плотно соединенная с подлежащей
тканью.
26. Патогенез
Пленчатый налет представляет собойнити фибрина, клетки эпителия,
эритроциты, лейкоциты, бактерий.
При одновременном поражении двух и
более органов диагностируется
комбинированная форма дифтерии.
Наиболее тяжело протекает
гипертоксическая форма, которая
может привести к смерти в течение
первых суток
27.
Пленки на миндалинах28. Эмиль Адольф фон Беринг ( 1854-1917)
В 1901 году Э.Беринг былудостоен Нобелевской
премии по физиологии и
медицине за работу над
«сывороточной терапией,
за её применение в
лечении дифтерии, что
открыло новые пути в
медицинской науке»
29.
Источником инфекции являетсячеловек - больной или
бактерионоситель.
Пути передачи:
воздушно-капельный;
воздушно-пылевой;
контактно-бытовой (предметный);
алиментарный (через молоко).
30. Лабораторная диагностика
Исследуемый материал:пленчатые налеты ( берут на границе
со здоровой тканью),
слизь из зева и носа,
пораженные участки кожи и слизистых
оболочек.
Материал высевают на элективные
среды.
31. Лабораторная диагностика
Отличие возбудителей дифтерии отдругих коринебактерий:
не ферментирует сахарозу
не разлагает мочевину (проба на
уреазу)
продуцирует фермент цистиназу
токсигенность
32.
Определение уреазной активности33.
Определение цистиназной активностиДля выявления способности
расщеплять цистин
используется среда Пизу
(сывороточный агар с
добавлением цистина и
уксуснокислого свинца в
качестве индикатора
выделяющегося H2S) посев
производится уколом в
столбик агара.
34.
Определение токсигенностиПроба Оухтерлони
35. АКДС
Адсорбированнаякоклюшнодифтерийно-столбнячная
вакцина, состоит из взвеси
убитых коклюшных микробов и
очищенных
дифтерийного
и
столбнячного
анатоксинов,
сорбированных
на
геле
гидроксида алюминия.
36. АКДС
Препарат вводят внутримышечноКурс вакцинации состоит из 3-х
прививок с интервалом 1,5 месяца
(3 мес., 4,5 мес. и 6 мес.)
Ревакцинацию проводят в 18 мес.
и в 6 лет.
АДС (АД) - в 14 лет и каждые 10 лет
37.
В настоящее время для оценкинапряженности антитоксического
иммунитета используют
серологические реакции (РНГА).
Титр антитоксинов 1/80 является
защитным.
Если антитела обнаруживаются в
более низких разведениях сыворотки,
требуется ревакцинация.
38. Возбудители туберкулеза. Характеристика. Патогенез и клиника.
39.
Туберкулёз – инфекционноезаболевание человека и животных,
сопровождающееся образованием
специфических гранулём в
различных органах и тканях.
Возможно поражение лёгких,
лимфатической системы, костей,
суставов, мочеполовых органов,
кожи, глаз, нервной системы
40.
Р. Кох в 1882 г.после 17 лет
исследований
обнаружил
возбудителя
туберкулеза
41.
В 1905 годуР. Кох за «исследования и
открытия, касающиеся
лечения туберкулеза», был
удостоен Нобелевской премии
по физиологии и медицине
42.
Семейство - MycobacteriaceaeРод – Mycobacterium
Вид:
M. tuberculosis - 92 % случаев
М. bоvis – 5% случаев
М. аfriсаnum - 3% случаев
М. avium
43. Mycobacterium tuberculosis
44. Mycobacterium bоvis
45. Биологические свойства
ПолиморфныНеподвижны
Спор и капсул не образуют
Облигатные аэробы
Оптимальная температура роста
37 - 38ºС
46. Клеточная стенка микобактерий
Отличается по строению от клеточныхстенок и грамположительных, и
грамотрицательных бактерий.
Выделяют три основных структурных
компонента:
пептидогликан,
арабиногалактан (полисахарид),
миколовые кислоты.
47. Клеточная стенка микобактерий
Наружные слои клеточной стенкимикобактерий представлены
поверхностными гликолипидами
(сульфолипидами).
В средней части клеточной стенки
основными компонентами являются
разветвленные жирные (миколовые)
кислоты.
Миколовые кислоты обеспечивают
высокую химическую устойчивость
микобактерий.
48. Клеточная стенка микобактерий
Внутренние слои образованыарабиногалактаном и пептидогликаном.
Пептидогликан непосредственно
примыкает к цитоплазматической
мембране.
Липоарабиноманнан заякорен на
цитоплазматической мембране,
пронизывает клеточную стенку и выходит
на ее поверхность. Концевые фрагменты
липоарабиноманнана подавляют
активацию Т-лимфоцитов и лейкоцитов,
вызывая нарушения иммунного ответа на
микобактерии.
49.
Строение клеточной стенкиMycobacterium tuberculosis
Поверхностные гликолипиды
Липоарабиноманнан
Миколовые кислоты (миколаты)
Арабиногалактан
Пептидогликан
Цитоплазматическая мембрана
50. Клеточная стенка микобактерий
Такая клеточная стенка гидрофобна и плохопроницаема для различных веществ, что
обуславливает сниженный метаболизм в
клетке, трудности окраски и устойчивость к
физическим и химическим факторам.
По методу Грама данные бактерии
окрашиваются плохо (условно
грамположительны).
Для окрашивания применяют метод Циля –
Нельсена для выявления кислотоустойчивых
бактерий.
51. метод Циля – Нельсена
1. На фиксированный мазок накладывают белуюфильтровальную бумагу и наливают карболовый
фуксин Циля. Препарат 2-3 раза подогревают в в
пламени до появления паров.
2. Препарат промывают водой, бумагу сбрасывают.
3. Препарат обесцвечивают в 5% растворе серной
кислоты.
4. Промывают водой.
5. Докрашивают синькой Леффлера 3-5 минут.
6. Промывают водой, высушивают, микроскопируют.
Кислотоустойчивые бактерии и споры - красного
цвета, а остальная микрофлора — синего цвета.
52. метод Циля – Нельсена
53.
Микобактерии содержат большое количестволипидов –
до 40% сухой массы клетки.
Обнаружено три фракции липидов:
фосфатидная (растворимая в эфире),
жировая (растворимая в эфире и ацетоне),
восковая (растворимая в эфире и
хлороформе)
54.
Размножение микобактерийпроисходит очень медленно.
Время генерации – 14–16 ч.
Из-за особенностей строение
клеточной стенки затруднена
поставка питательных веществ, что
снижает метаболическую
активность клетки. Видимый рост
на средах – 21–28 дней.
55. Резистентность
Микобактерии одни из самых устойчивых кдействию физических и химических факторов
неспорообразующие бактерии.
В высохшей мокроте больного они сохраняют
жизнеспособность и вирулентность в течение 5 – 6
месяцев.
Рассеянный солнечный свет вызывает их гибель
лишь через 8 – 10 суток.
В мокроте при кипячении погибают через 5 – 7
мин.
Относительно устойчивы к действию обычных
дезинфицирующих веществ: 5%-ный раствор
фенола вызывает гибель туберкулезных палочек
лишь через 6 часов.
56.
Возбудители туберкулеза оченьтребовательны к питательным средам.
Факторы роста – глицерин,
аминокислоты.
Растут на картофельно-глицериновых,
яично-глицериновых и синтетических
средах (среда Сотона).
Во все эти среды добавляют вещества,
которые ингибируют рост
контаминирующей флоры.
57. среда Левенштейна – Йенсена
58. среда Левенштейна – Йенсена M. tuberculosis
59. среда Левенштейна – Йенсена М. bоvis
60.
Жидкая среда – глицериновыйбульон
На жидких средах растут в виде пленки.
Пленка сначала нежная, сухая, со
временем утолщается, становится
бугристо-морщинистой с желтоватым
оттенком.
Среда при этом непрозрачная.
M. tuberculosis – 7-10 дней
М. bоvis – 1,5 – 2 мес.
61.
Главным фактором патогенностимикобактерий является - корд-фактор –
токсический гликолипид, состоящий из
трегалозы и димиколата. Располагается на
поверхности и в толще клеточной стенки.
Он разрушает митохондрии клеток
инфицированного организма, тем самым
нарушая функцию дыхания.
( от англ. соrd – жгут, веревка)
62. Корд-фактор
оказывает токсическое действие на ткани,подавляет миграцию лейкоцитов,
повреждает мембраны митохондрий,
ингибирует образование фаголизосомы,
обусловливает “скученный тип роста” –
вирулентные штаммы микобактерий на
жидких средах растут в виде “извилистых
тяжей” (или кос), в которых клетки
микобактерий располагаются
параллельными цепочками
63. Корд-фактор
64. Факторы вирулентности
липиды и липидосодержащиеструктуры
сульфатиды (серосодержащие
гликолипиды), усиливающие
токсическое и
антифагоцитарное действие
корд-фактора
65. Специфическое туберкулезное воспаление
АльтерацияЭкссудация
Пролиферация
Туберкулезный бугорок
66. Специфическое туберкулезное воспаление
Альтерация – повреждение ткани вплоть донекроза.
Экссудация – характеризуется появлением в
зоне воспаления серозного пропитывания,
выпадения фибрина, клеточных скоплений с
преобладанием мононуклеарных фагоцитов.
Пролиферация – усиленное размножение
клеточных элементов, их трансформацией в
очаге воспаления с образованием гранулем
(бугорков).
67. Туберкулезный бугорок
в центре бугорка - аморфный тканевойдетрит
по периферии - расположено
несколько слоев эпителиоидных
клеток, среди которых клетки Пирогова
– Лангганса
более поверхностно – лимфоидные
клетки, мононуклеарные фагоциты
образование гранулем представляет
собой реакцию ГЗТ
68.
Гранулематозная гиперчувствительностьПролиферирующие
фибробласты
Фагосома
Инфекционный
агент
Клетки
МакрофагТ-лимфоциты
Эпителиоидные
Пирогова-Лангганса
клетки
69. Формирование первичного туберкулезного комплекса
Туберкулезный бугорокПоражение лимфатических
путей
Поражение лимфатических
узлов (лимфаденит)
70. Развитие заболевания
В развитии туберкулеза выделяют два периода.Первый период возникает в ответ на первичное
экзогенное заражение ранее неинфицированных
людей.
Этот период может завершиться развитием
первичного туберкулеза, или спонтанным
излечиванием.
При первичном туберкулезе в зоне внедрения
возбудитель захватывается макрофагами, в
результате чего развивается гранулематозная
реакция. Затем микобактерии преодолевают этот
барьер, проникают в регионарные лимфатические
узлы, кровь и различные органы. Первичный
туберкулез в результате экзогенного заражения
развивается у 7-10% инфицированных лиц (детей).
71. Развитие заболевания
При спонтанном излечивании формируетсяпервичный туберкулезный комплекс
( очаг воспаления, в котором длительное
время сохраняется возбудитель в
дремлющем состоянии).
У таких людей формируется
приобретенный иммунитет.
Сохранение возбудителя в очагах
персистенции не только поддерживает
иммунитет, но одновременно создает риск
эндогенного инфицирования.
72. Развитие заболевания
Второй период связан с вторичным экзогенным илиэндогенным инфицированием микобактериями,
сохранившимися в первичном очаге.
Вторичный туберкулез возникает в иммунном
организме у ранее инфицированных людей
(взрослых).
При этом развиваются разнообразные клинические
формы туберкулеза (чаще всего поражаются органы
дыхания ).
Эндогенная реактивация микобактерий может
наступить в течение любого срока после первичного
туберкулеза (от нескольких недель до десятков лет)
в результате неблагоприятных социальноэкономических условий, недостаточности питания,
сопутствующих заболеваний (диабет).
73.
У ослабленных людей, на фонеиммунодефицитного состояния, может
произойти выход содержимого
гранулемы в кровоток, что приводит к
развитию диссеминированного
туберкулеза с образованием множества
гранулем в различных органах.
Прогноз неблагоприятный.
74. Приобретенный иммунитет
Формируется через 6-8 недель послеинфицирования
Формируется как клеточный, так и
гуморальный иммунитет
Нестерильный (инфекционный
иммунитет) – иммунитет сохраняется
до тех пор, пока в организме есть
возбудитель
75. Источники инфекции
Основным источником инфекции притуберкулезе является больной человек.
В 90 – 95% случаев заражение
происходит с помощью аэрогенного
механизма.
Пути
воздушно-капельный
воздушно-пылевой
контактно-бытовой
Другие пути проникновения инфекции
(через кожу, конъюнктиву глаз,
миндалины, через плаценту)
76. Источники инфекции
Реже заражение человекатуберкулезом происходит
алиментарным путем (Mycobacterium
bоvis)- при употреблении молока и
мяса от больных животных при
недостаточной термической
обработке, либо при контакте.
Крупный рогатый скот, козы, овцы,
свиньи, собаки и кошки.
77. Лабораторная диагностика
бактериоскопический методбактериологический метод
серологический метод
биологический метод
метод кожно-аллергических
проб
молекулярно-биологический
метод (ПЦР)
78. Бактериоскопический метод
1.2.
В мазках, окрашенных по Цилю-Нильсену,
обнаруживают кислотоустойчивые палочки
Используют методы обогащения центрифугирование и флотацию:
исследуемый материал обрабатывают смесью
растворов NaCl и NaOH, центрифугируют и
микроскопируют осадок;
исследуемый материал обрабатывают смесью
NaOH, дистиллированной воды, ксилола или
бензола, встряхивают до образования пены, пену
извлекают и готовят мазки
79. Бактериологический метод
Достоинство метода – возможность получениячистой культуры, что позволяет оценить ее
вирулентность и определить
чувствительность к лекарственным
препаратам. Широко применяется
бактериологический метод и для контроля за
эффективностью проводимой терапии.
Материал засевают на плотные питательные
среды. Вирулентность выделенной культуры
определяют по наличию корд-фактора.
Недостаток – длительность получения
результата (до 12 недель).
80. Ускоренные методы культивирования метод микрокультур Прайса
Мокроту наносят толстым слоем на несколько узкихпредметных стекол.
Высушенные мазки берут стерильным пинцетом и
погружают на 15-20 мин в пробирки с 2% раствором
серной кислоты, а затем трижды промывают стерильным
раствором хлорида натрия для удаления кислоты.
После этого препарат помещают в пробирки или флаконы
с жидкой средой Сотона или цитратной кровью.
Посевы выращивают в термостате при 37-38 ° С.
Через 3-4 суток стекла с мазками извлекают, фиксируют,
окрашивают по Цилю-Нильсену и микроскопируют.
Вирулентные микрокультуры в препаратах образуют
жгуты или «косы», которые формируются под влиянием
корд-фактора. Максимальный рост микрокультур
отмечается на 7-10 день.
81. метод микрокультур Прайса
82.
Биологический метод. Морским свинкамподкожно или внутрибрюшинно вводят
исследуемый материал. Через 1 – 2 мес. у
животных развивается генерализованный
туберкулез. Биологический метод является
наиболее чувствительным, поскольку он
позволяет выявить от 1 до 5 микробных
клеток в исследуемом материале.
Серологический метод. Предложены РСК,
РНГА, иммуноферментный анализ,
иммуноблотинг.
83. Метод кожно-аллергических проб
Туберкулиновая проба (реакцияМанту) представляет собой кожную
пробу, направленную на выявление
наличия иммунного ответа на
введение туберкулина.
Наличие выраженной кожной реакции
свидетельствует о наличии
напряжённого иммунитета.
84. Метод кожно-аллергических проб
Туберкулин - неполный антиген (гаптен)микобактерии (M. tuberculosis и М. bоvis),
используемый для диагностики
туберкулёза.
Очищенный туберкулин (ППД) - purified
protein derivative (PPD) - изготавливают из
смеси убитых нагреванием фильтратов
культуры микобактерий, очищенных
ультрафильтрацией, осажденных
трихлоруксусной кислотой, обработанных
этиловым спиртом и эфиром.
85. проба Манту
86. Проба Манту
Основные принципы интерпретациирезультатов пробы Манту:
отрицательная
положительная
К признакам инфицирования по
результатам туберкулинодиагностики
относятся:
вираж туберкулиновой пробы;
гиперергическая реакция;
постепенное, в течение нескольких лет, усиление
чувствительности к туберкулину с образованием
инфильтрата размерами 12 мм и более.
87. Проба Манту
Вираж туберкулиновой пробы — это переходотрицательной реакции Манту в положительную
(не связанный с предшествующей вакцинацией)
или увеличение диаметра папулы по сравнению с
результатом предыдущей пробы на 6 и более мм.
Гиперергическая реакция — диаметр папулы
превышает 17 мм или имеются выраженные
признаки воспаления (реакция лимфоузлов,
изъязвление кожи).
88. Диаскинтест (Diaskintest)
Диаскинтест раствор для внутрикожноговведения представляет собой
рекомбинантный белок, который
продуцируют генетически
модифицированные культуры Escherichia coli
Диаскинтест содержит два антигена, которые
присутствуют в вирулентных штаммах
Mycobacterium tuberculosis и отсутствуют в
вакцинном штамме БЦЖ.
89. Диаскинтест (Diaskintest)
Механизм действия препаратаДиаскинтест основан на выявлении
клеточного иммунного ответа на
специфические для микобактерий
туберкулеза антигены.
У пациентов с туберкулезной
инфекцией введение препарата
Диаскинтест приводит к развитию
специфической кожной реакции,
которая является проявлением
гиперчувствительности замедленного
типа.
90. Диаскинтест (Diaskintest)
Диаскинтест применяют для проведениявнутрикожной пробы у пациентов всех
возрастных групп с целью диагностики
туберкулеза, проведения оценки
активности процесса и выявления
пациентов с высоким риском развития
активного туберкулезного процесса.
91. Диаскинтест (Diaskintest)
Оценка результата пробы сприменением препарата Диаскинтест
проводится спустя 72 часа после
проведения пробы.
Оценку проводят, измеряя поперечный
размер гиперемии и папулы
(инфильтрата).
Размер вычисляют в миллиметрах.
92.
93.
Молекулярнобиологический метод(ПЦР)
94. классификация противотуберкулезных препаратов
1 ряд – наиболее эффективные препараты- изониазид
2 ряд – препараты средней эффективности
- этамбутол, канамицин, циклосерин
3 ряд – малые противотуберкулезные
препараты (ПАСК – производные
парааминосалициловой кислоты,
антиметаболит)
95. Специфическая профилактика
вакцина БЦЖ – BCGBCG - Bacille Calmette – Guerin
получена А. Кальметтом и Ш. Гереном
на основе аттенуированного штамма M.
bovis
путем длительного пассирования на
картофельно-глицериновой среде с
добавлением желчи
было сделано 230 пассажей в течение 13 лет
96.
97. Специфическая профилактика
Вводится новорожденнымна 2 - 7-й день жизни внутрикожно
Первая ревакцинация в 7 лет
Вторая ревакцинация в 14 лет
98.
Туберкулез является одной из 10 ведущих причин смертив мире. Согласно данным ВОЗ ежегодно в мире
туберкулезом заболевают до 10 миллионов человек, и
около 1,5 миллионов человек умирают от этой болезни, в
т.ч. 20% от ко-инфекции ВИЧ и туберкулез.
В Российской Федерации число заболевших за период с
2000 по 2019 год снизилось более, чем в 2 раза (с 133 229
человек в 2000 году до 60 531 человек в 2019 году), а
умерших от туберкулеза – более, чем в 4 раза (с 29 966
человек в 2000 году до 7 264 человек в 2019 году), что
является результатом приоритетного отношения
государства к проблеме туберкулеза.
В 2019 году заболеваемость туберкулезом – по сравнению с
2018 годом снизилась на 7,2 % (с 44,4 до 41,2 на 100 000
населения), а смертность от туберкулеза - на 11,8 % (с 5,9
до 5,2 на 100 тыс. населения.).
99.
24 марта 1882 г. Р. Кох сообщило том, что ему удалось выделить
бактерию, вызывающую
туберкулез.
В связи с этим ВОЗ объявила
24 марта
Всемирным днем борьбы с
туберкулезом

medicine
medicine








